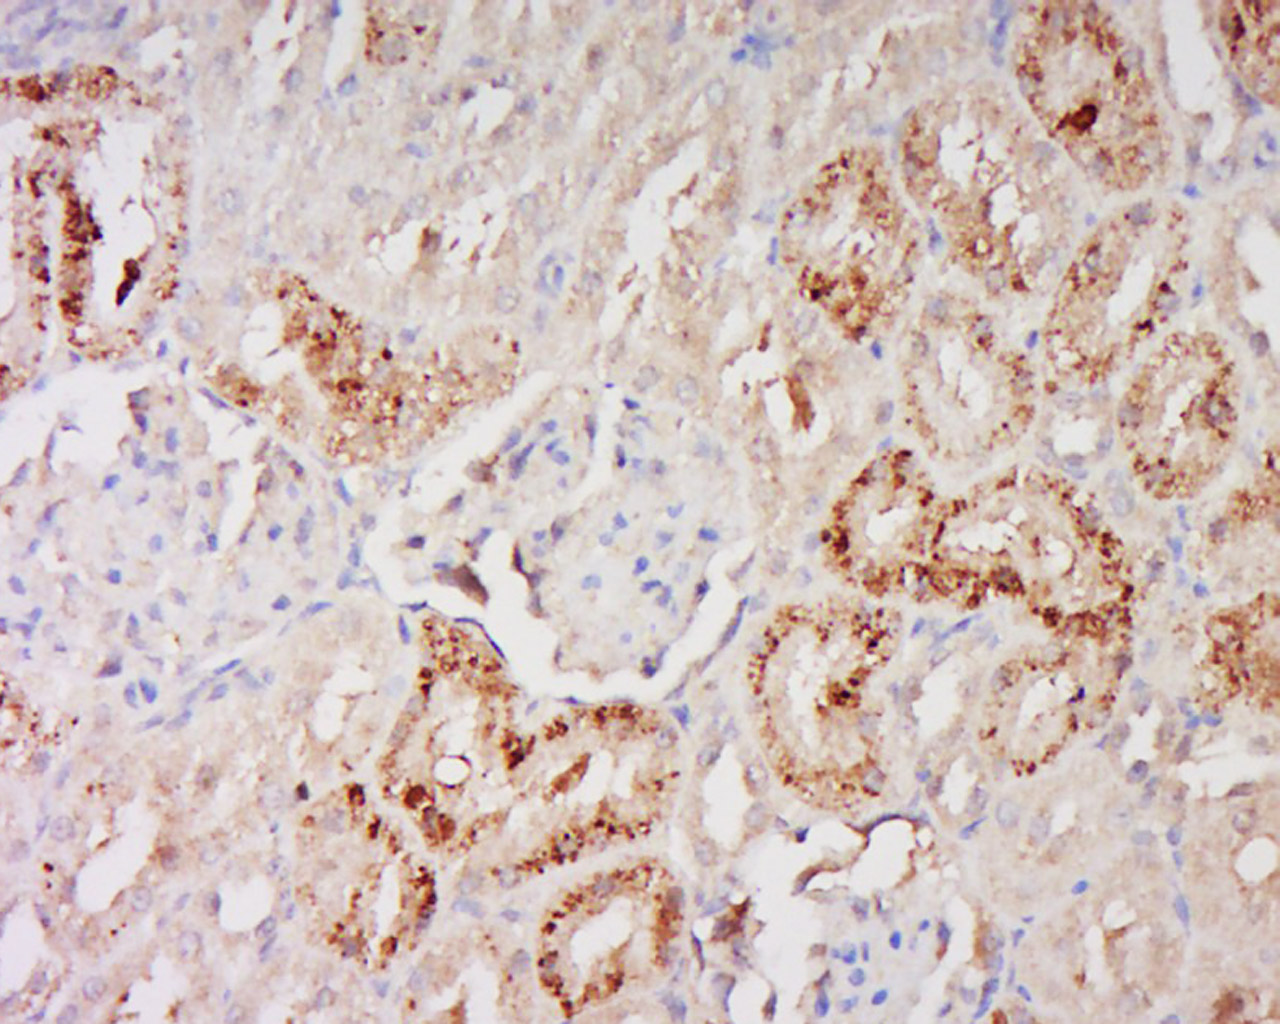
phospho-Glucocorticoid Recepto

相关产品推荐更多 >

PLCG 2 Rabbit pAb, FITC conjugated(bs-3532R-FITC)-100ul
¥2980
CRMP2 Rabbit pAb, Biotin conjugated(bs-1790R-Bio)-100ul
¥2980
TTF1/NKX2-1 Rabbit pAb, APC conjugated(bs-10539R-APC)-100ul
¥2980
HDAC8 Rabbit pAb(bs-2891R)-50ul/100ul/200ul
¥1180
H2AX (Ubiquityl Lys119) Rabbit pAb, PerCP-Cy7 conjugated(bs-8571R-PerCP-Cy7)-100ul
¥2980
万千商家帮你免费找货
0 人在求购买到急需产品
- 详细信息
- 文献和实验
- 技术资料
- 应用范围:
产品信息以Bioss网站为准
- 规格:
50ul/100ul/200ul
| 规格: | 50ul | 产品价格: | ¥1180.0 |
|---|---|---|---|
| 规格: | 100ul | 产品价格: | ¥1980.0 |
| 规格: | 200ul | 产品价格: | ¥2800.0 |
| 产品编号 | bs-13384R |
| 英文名称 | phospho-Glucocorticoid Receptor (Ser226) Rabbit pAb |
| 中文名称 | 磷酸化糖皮质激素受体抗体 |
| 英文别名 | Glucocorticoid Receptor(phospho S226); p-Glucocorticoid Receptor(phospho S226); Glucocorticoid Receptor; GCCR; GCR; GR; Nuclear receptor subfamily 3 group C member 1; Glucocorticoid receptor lymphocyte; GRL; Grl1; Nr3c1; NR3C1; GCR_HUMAN. |
| 产品应用 | IHC-P=1:100-500, IHC-F=1:100-500, IF=1:100-500 Not yet tested in other applications. |
| 交叉反应 | Human, Rat (Mouse) |
| 抗体来源 | Rabbit |
| 免疫原 | KLH conjugated Synthesised phosphopeptide derived from human Glucocorticoid Receptor around the phosphorylation site of Ser226 |
| 亚型 | IgG |
| 性状 | Liquid |
| 纯化方法 | affinity purified by Protein A |
| 克隆类型 | Polyclonal |
| 理论分子量 | 85 kDa |
| 浓度 | 1mg/ml |
| 储存液 | 0.01M TBS (pH7.4) with 1% BSA, 0.02% Proclin300 and 50% Glycerol. |
| 研究领域 | Cancer > Signal transduction > Nuclear signaling > Nuclear hormone receptors Epigenetics and Nuclear Signaling > Nuclear Signaling Pathways > Nuclear Receptors > Corticoid Signal Transduction > Signaling Pathway > Nuclear Signaling > Nuclear Hormone Receptors > Corticoid |
| 亚基 | Heteromultimeric cytoplasmic complex with HSP90, HSP70, and FKBP5 or another immunophilin, or the immunophilin homolog PPP5C. Directly interacts with UNC45A. Upon ligand binding FKBP5 dissociates from the complex and FKBP4 takes its place, thereby linking the complex to dynein and mediating transport to the nucleus, where the complex dissociates (By similarity). Binds to DNA as a homodimer, and as a heterodimer with NR3C2 or the retinoid X receptor. Binds STAT5A and STAT5B homodimers and heterodimers. Interacts with NRIP1, POU2F1, POU2F2 and TRIM28. Interacts with NCOA1, NCOA3, SMARCA4, SMARCC1, SMARCD1, and SMARCE1 (By similarity). Interacts with several coactivator complexes, including the SMARCA4 complex, CREBBP/EP300, TADA2L and p160 coactivators such as NCOA2 and NCOA6. Interaction with BAG1 inhibits transactivation. Interacts with HEXIM1, PELP1 and TGFB1I1. |
| 亚细胞定位 | Cytoplasm. Nucleus. Note=Cytoplasmic in the absence of ligand, nuclear after ligand-binding.
Isoform Beta: Nucleus. Note=Localized largely in the nucleus. |
| 组织特异性 | Widely expressed. In the heart, detected in left and right atria, left and right ventricles, aorta, apex, intraventricular septum, and atrioventricular node as well as whole adult and fetal heart. |
| 翻译后修饰 | Increased proteasome-mediated degradation in response to glucocorticoids.
Phosphorylated in the absence of hormone; becomes hyperphosphorylated in the presence of glucocorticoid. The Ser-203-phosphorylated form is mainly cytoplasmic, and the Ser-211-phosphorylated form is nuclear. Transcriptional activity correlates with the amount of phosphorylation at Ser-211. Sumoylated; this reduces transcription transactivation. Ubiquitinated; restricts glucocorticoid-mediated transcriptional signalin. |
| 相似性 | Belongs to the nuclear hormone receptor family. NR3 subfamily.
Contains 1 nuclear receptor DNA-binding domain. |
| 功能 | Receptor for glucocorticoids (GC). Has a dual mode of action: as a transcription factor that binds to glucocorticoid response elements (GRE) and as a modulator of other transcription factors. Affects inflammatory responses, cellular proliferation and differentiation in target tissues. Could act as a coactivator for STAT5-dependent transcription upon growth hormone (GH) stimulation and could reveal an essential role of hepatic GR in the control of body growth. Involved in chromatin remodeling. Plays a significant role in transactivation. Involved in nuclear translocation. |
| 保存条件 | Shipped at 4℃. Store at -20℃ for one year. Avoid repeated freeze/thaw cycles. |
| 注意事项 | This product as supplied is intended for research use only, not for use in human, therapeutic or diagnostic applications. |
| 背景资料 | Steroid receptors are ligand-dependent, intracellular proteins that stimulate transcription of specific genes by binding to specific DNA sequences following activation by the appropriate hormone. Glucocorticoids are a family of steroids necessary for the regulation of energy metabolism and the immune and inflammatory responses. These compounds exert their effect through their interaction with the glucocoticoid receptor (GR) and that complex's subsequent association with DNA. All normal mammalian tissues examined to date have been shown to contain glucocorticoid receptor. |
| 应用 | 推荐稀释比例 |
| {IHC-P} | {1:100-500} |
| {IHC-F} | {1:100-500} |
| {IF} | {1:100-500} |
Antigen retrieval: citrate buffer ( 0.01M, pH 6.0 ), Boiling bathing for 15min; Block endogenous peroxidase by 3% Hydrogen peroxide for 30min; Blocking buffer (normal goat serum,C-0005) at 37℃ for 20 min;
Incubation: Anti-Phospho-Glucocorticoid Receptor (Ser226) Polyclonal Antibody, Unconjugated(bs-13384R) 1:500, overnight at 4°C, followed by conjugation to the secondary antibody(SP-0023) and DAB(C-0010) staining

Antigen retrieval: citrate buffer ( 0.01M, pH 6.0 ), Boiling bathing for 15min; Block endogenous peroxidase by 3% Hydrogen peroxide for 30min; Blocking buffer (normal goat serum,C-0005) at 37℃ for 20 min;
Incubation:Anti-Phospho-Glucocorticoid Receptor (Ser226) Polyclonal Antibody, Unconjugated(bs-13384R) 1:500, overnight at 4°C, followed by conjugation to the secondary antibody(SP-0023) and DAB(C-0010) staining
风险提示:丁香通仅作为第三方平台,为商家信息发布提供平台空间。用户咨询产品时请注意保护个人信息及财产安全,合理判断,谨慎选购商品,商家和用户对交易行为负责。对于医疗器械类产品,请先查证核实企业经营资质和医疗器械产品注册证情况。
文献和实验[IF={{ 2.7 }}] {Ding, Ying-xue, et al. "Regulation of glucocorticoid-related genes and receptors/regulatory enzyme expression in intrauterine growth restriction filial rats." Life Sciences (2016).} {WB} {="Rat"}
技术资料暂无技术资料 索取技术资料





